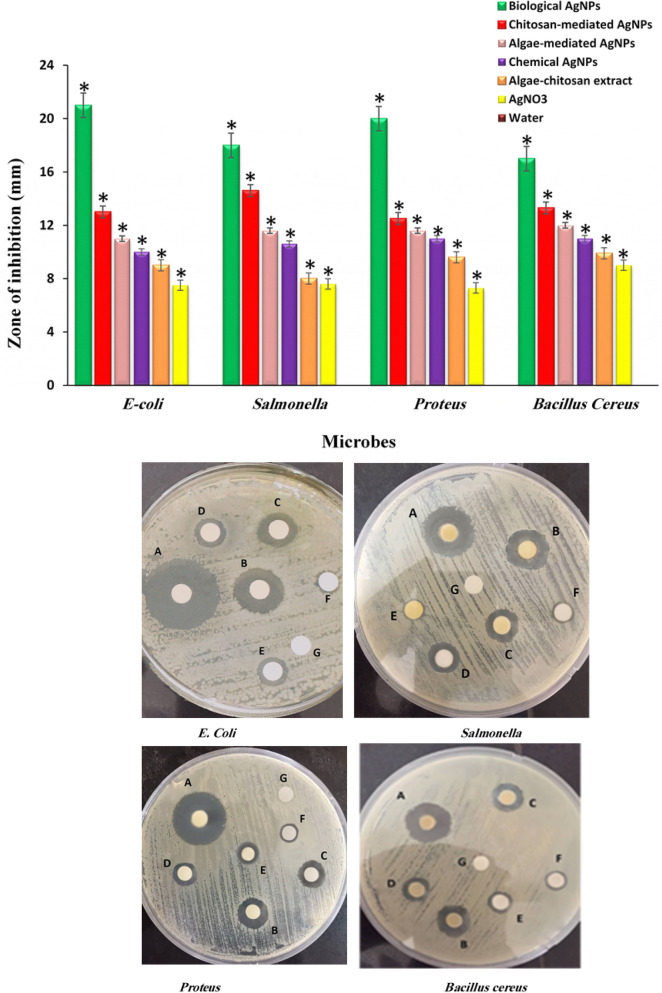

Abstract
The present study reports the synergistic antibacterial activity of biosynthesized silver nanoparticles (AgNPs) with the aid of a combination of chitosan and seaweed-derived polyphenols as a green synthetic route. Under optimum synthesis conditions, the rapid color change from yellowish to dark brown and UV–visible absorption peak at 425 confirmed the initial formation of AgNPs. DLS, TEM, XRD, and EDX analyses revealed the spherical shape of pure biogenic AgNPs with a mean diameter size of 12 nm ± 1.5 nm, and a face-centered cubic crystal structure, respectively. FTIR and TGA results indicated the significant contribution of chitosan and polyphenol components into silver ions bioreduction and thermal stability of freshly formed AgNPs. Long-term colloidal stability of AgNPs was obtained after 6-month storage at room temperature. The bio-prepared AgNPs possessed a negative surface charge with a zeta potential value of − 27 mV. In contrast to naked chemical silver nanoparticles, the green Ag nanosamples demonstrated the distinct synergistic antibacterial in vitro toward all selected human pathogens presumably due to the presence of high content of biomolecules on their surface. The results show that synergy between chitosan and polyphenol results in the enhancement of bactericidal properties of biogenic AgNPs. We also highlighted the underlying mechanism involved in AgNPs formation based on nucleophile–electrophile interaction.
Subject terms: Nanobiotechnology, Nanoscale materials, Techniques and instrumentation, Green chemistry, Medicinal chemistry, Organic chemistry, Chemical synthesis, Biosynthesis
Introduction
Green nanotechnology as an emerging alternative technology is constructed on the ecological synthesis of nanoparticles by employing the capability of naturally occurring materials to generate various nanoparticles through implementing sustainable processes1. The traditional chemical and physical synthesis approaches are expensive, and highly likely produce hazardous chemicals, hence sternly influencing the environment. In addition to their high cost, they comprise detrimental reductants, for instance, sodium citrate or borohydride, and time-consuming synthesis procedures. In contrast, green synthetic procedures have gained rising popularity as they target curtailing toxic wastes and provide a benign atmosphere for promoting environmental sustainability. They hold intriguing advantages such as simplicity, low cost, and environmental compatibility through product design and process optimization. The underlying principles for the biosynthesis of nanomaterials including biocompatible reducing and stabilizing agents, nontoxic precursors, and the selection of solvent medium should be considered in a green synthesis approach2. In recent years, various natural materials such as plant extracts and marine organisms (yeast, bacteria, algae, fungi, etc.) have been exploited for NPs synthesis3,4. They function as a potential biofactory for the reduction and stabilization of the biofabricated nanoparticles owing to a great variety of their secondary metabolite’s contents such as polysaccharides, polyphenols, chitosan, alkaloids, fiber, and flavonoids5. Generally, the advantages of green synthesis over chemical and physical methods could assign to auspicious attributes such as environment friendly, less biohazard, effortlessness of improvement, and decrease the cost of the production process6–9.
Algae are unicellular or multicellular photosynthetic organisms that ecologically and economically of great importance. These simple autotrophic organisms typically dwell in copiously and extremely versatile groups in various environments such as the intertidal rocky shore, marine water, and freshwater10. Algae are classified as macroalgae and microalgae of which consider a valuable source in a wide range of commercial products, namely, pertaining to cosmetics, agriculture, and medicine. Owing to the presence of electron-rich bioactive materials in marine algae biomass, they are a superior contender for the eco-friendly synthesis of different types of metallic nanoparticles11.
Chitosan is a linear polysaccharide that obtains from the deacetylation of chitin, a naturally occurring polymer present in shells of prawn and other crustaceans, using an alkaline substance. it is one of the frequently benefited biopolymers for a myriad of applications such as fabrics, cosmetics, water treatment, and food processing. The presence of a large number of valuable free primary amino groups increases the hydrophilic nature of the chitosan in an aqueous solution in which aids its interaction with the nanoparticles, polymers, cells, and drugs. Moreover, chitosan biopolymers as sustainable chitin derivatives have been extensively scrutinized in the biomedical industry due to intriguing features such as biocompatibility, low allergenicity, biodegradability, and non-toxicity12,13. More specifically, literature has been overwhelmed with a variety of reports referring to the multiple roles of chitosan in nanoparticles synthesis, stabilization, and their applications14,15.
Bacteria are prokaryotes, unicellular organisms which present in colossal numbers, in all environment. They inhabit either inside or outside other living entities and are neither plants nor animals. some of these microscopic creatures are detrimental and cause severe human infections. In order to inhibit and treat infectious bacteria medicines such as antibiotic drugs are being used to devastate bacteria cell members or curb their growth. However, some bacteria strains have developed resistance to the penetration of antimicrobial agents as bacteria conceal through varying responses to the use of these medicines by alteration of their membrane permeability. Hence, a number of effective therapeutic methods such as natural antibiotics (garlic, honey, ginger, etc.)16, and metal-based nanomedicine (e.g., silver, gold, copper)17, have been proposed to improve the antibacterial properties of antimicrobial agents against bacteria tenacity.
Nobel silver nanoparticles (AgNPs) have attracted enormous attention due to their broad-spectrum application in growing demand goods such as cosmetics, textiles, electronics, biosensors, catalysts, and medicine products18. As a result of intrinsic antibacterial efficiency and the unique physicochemical properties, AgNPs are progressively incorporated with other materials in form of a bimetallic, alloy, and core–shell nanostructures for copious biomedical applications3. Due to environmental concern on chemical-based synthetic methods risks, implementing novel biological approaches as a valuable alternative has become a research hotspot for the biosynthesis of AgNPs19. In addition, there is the sheer volume of reports have used miscellaneous biological sources for the synthesis of AgNPs including plant (extracts of seeds, root, peel, stems, flowers, leaves, and fruits), marine microbes (algae, fungi, bacteria), and other biosources (egg whites, agriculture waste)20,21. Each method has been reported as a reliable green template for biofabrication of AgNPs on account of the reducing and stabilizing properties of phytochemicals that exist in microorganisms22. The essential characteristics of bioproduced nanoparticles such as shape and size are particularly attributed to the type and biochemical’s constituents of selected natural sources. It is worth mentioning that no study has been reported yet examining the effects of collective biomaterials on nanoparticle fabrication and their biological activities. Thus, this research focuses on the combinative effect of abundant, and low cost of marine-derived materials of biopolymer chitosan23,24 and the brown marine algae extract25 as an extracellular green platform on biofabrication AgNPs. The antimicrobial properties of biomimetic AgNPs toward human pathogenic bacteria were compared to raw extract and commercial samples. Moreover, this work emphasizes the mechanistic aspects of biochemical's impact on the morphology, size, and distribution of green AgNPs. biochemical's impact.
Results and discussion
UV–visible spectroscopy characterization
The primary indication of successful biosynthesis of noble metal nanoparticles is the change in the color of the solution. Hence, a swift color change from an approximately pale yellow to a yellowish-brown was clearly observed in the solution due to the bioreduction of silver ion (Ag+) to metallic AgNPs (Fig. 1b). UV–Vis technique is one of the most important methods for identifying the formation of metal nanoparticles indicating the existence of metal surface plasmon resonance26. Scanning the reaction solution was performed in the wavelength range of 360–600 nm using the Analytik Jena AG model of UV–Vis spectrophotometer. While the UV–vis absorption spectrum reveals no peak for chitosan-algae extract medium it demonstrates a conspicuous peak at λmax = 425 nm indicating the induction of surface plasmon resonance (SPR) of the biosynthesized AgNPs (Fig. 1b)27. In addition, the lack of observing any peak in the region of 470 to 700 relatively indicates the absence of agglomeration which further strengthens the stability of bio-assisted AgNPs28. In literature, the characteristic absorbance peak greater than 400 nm in UV–vis spectrum is assigned as a confirmation index for AgNPs formation29.
Figure 1.
UV–visible spectra of (a) chitosan-algae extract, freshly prepared AgNPs solution (b), and stability of AgNPs after six months (c); inset shows the visible color change in the reaction mixture (a,b).
Stability of bio-assisted AgNPs
Figure 1c illustrates the UV–vis absorption spectrum of the biosynthesized AgNPs after a storage period of 180 days to examine the stability of the AgNPs in the room temperature. In comparison to initial bioproduced AgNPs solution at 45 min (Fig. 1b), neither significant shift in absorption peak nor change in the color of the solution was observed, indicating ultra-high stability of bioprepared AgNPs over a prolonged period.
Optimization of reaction parameters
In order to obtain AgNPs of fine size and shape, optimization of the main reaction parameters was performed with contact time (5–45 min), silver salt precursor concentration (0.1–0.5%) and chitosan-algae extract proportion (4:1, 3:2, 2.5:2.5, 2:3, 1:4 ml), respectively. The samples were subjected to UV–vis spectrometry analysis to study the impact of parameters on the rate of biosynthesis of AgNPs (Figs. 1S-3S, see supplementary). The results indicated that the optimal operating conditions of the proposed biological process for biofabrication of marine-mediated AgNPs were 0.5% AgNO3, time of 45 min, and 2:3 ml proportion of chitosan to algae extract.
X-ray diffraction patterns of AgNPs
The crystallinity of nanoparticles can be determined by means of X-ray diffraction (XRD) analysis. XRD pattern for AgNPs biofabricated from combinatorial chitosan-algae extract demonstrates sharp diffraction peaks with high intensity and low full width half maximum (FWHM) for silver at 38.45°, 46.38°, 64.64°, and 78.99° which indicate that the particles were crystalline in nature (Fig. 2). Furthermore, Miller indices (h k l) corresponding to (111), (200), (220), and (311) planes may be attributed to the face-centered cubic (FCC) crystal structure of metallic silver atoms30. The average crystallite sizes of AgNPs obtained from the Debye–Scherrer formula is 10 nm. As a result, XRD analysis confirmed the formation of the AgNPs through the green-design methodology which in accordance with the XRD JCPDS reference pattern of the bulk silver reported by other similar studies31. It can be noted that the other few unassigned peaks with relatively lower intensities in the X-ray diffraction pattern may attribute to the crystallization of extract-derived inorganic or organic components on the surface of AgNPs. Based on XRD data, the measured value of the lattice parameter of biogenic AgNPs was 0.405 nm which was consistent with the standard lattice parameter of metallic silver (0.409 nm) (Fig. 2)32,33.
Figure 2.
XRD pattern of AgNPs biosynthesized from the mixture of algae extract and chitosan.
DLS analysis
Dynamic light scattering (DLS) is deemed as an effective and index of a statistically reliable tool for determining the particle size distribution of nanoscale materials dispersed in solution or colloidal suspensions34. Figure 3a shows the distribution of biosynthesized nanoparticles using a combination of aqueous extract marine algae and biopolymer chitosan. DLS result confirmed polydisperse particles with a diameter of 27 nm and an intensity of 98% for marine-mediated AgNPs. The obtained size is not only related to the size of the metal core of the nanoparticles, but also to the size of the biomaterial absorbed to the surface of the AgNPs and the electrical double-layer (solvent wall) that moves between the particles. Hence, the size of the particles also depends on the materials that are in the colloid. As a result, the size of the particles is often larger than other macroscopic techniques such as TEM35. As the results of DLS measurements, the polydispersity index (PDI) of AgNPs was determined as 0.15 indicating a monodispersed population of nanoparticles with respect to the size distribution29,36. Interestingly, the zeta potential analysis revealed that bio-assisted colloidal AgNPs are highly stable in nature showing negatively surface charge with a value of − 27 mV (Fig. 3b). This result indicates the presence of repulsive forces may curtail aggregation and agglomeration of particles resulting in the long-term stability of colloids37.
Figure 3.
(a) DLS analysis and (b) Zeta potential of AgNPs biosynthesized from a mixture of marine algae extract and biopolymer chitosan.
TEM analysis
The shape and size of the bioinspired AgNPs at the scale bar of 50 nm were investigated by the TEM technique (Fig. 4a). TEM image indicates that the majority of the silver particles were spherical in shape. Histogram particle size distribution (Fig. 4b) of the synthesized AgNPs exhibits the size distribution of particles from 5–20 nm with a mean size of 12 nm ± 1.5 nm, supporting UV–vis, XRD, and DLS findings of biologically produced AgNPs (Figs. 1, 2, 3).
Figure 4.
(a) TEM image (magnitude: 35.97 KX) of silver nanoparticles synthesized from a marine mixture of algae extract and chitosan, (b) histogram of the particle size distribution of the biosynthesized AgNPs.
FTIR analysis
Marine biopolymer chitosan and biochemicals present in the aqueous algae extract responsible for potential bioreduction of silver cations as well as proficient stabilization of AgNPs were scrutinized using Fourier-Transform Infrared Spectroscopic (FTIR) technique38. Figure 5a,b presents the FTIR spectra of the mixture of marine algae-chitosan extract and biological AgNPs. Approximately in all spectra the key functional groups including hydroxyl, carbonyl, amine is observed. The fairly wide vibrational bands observed in the range of 3384–3412 cm−1 are corresponded to N‒H and O‒H stretching, resulting from the intramolecular hydrogen bonds. The absorption bands of aliphatic C–H symmetric stretching can be observed at around 2930 cm−1. The peak appeared at 2335 cm−1 is associated with the stretching vibration of adsorbed CO2 by sample. The presence of the carbonyl group (C=O) can be confirmed at 1631 cm−1. Medium signal of N‒H bending vibrations centered at 1549 cm−1 confirms the presence of primary amine in chitosan as well as residual amide of peptide in algae extract. The advent of quite a strong absorption peak at 1336 cm−1 can be assigned to C‒N stretching of amino and/or amid entity. The sharp bands at 1066 and 1028 cm−1 are corresponded to C‒O stretching. The IR band at 745 cm−1 is originated from C‒O‒C bending vibrations in glycosidic linkages. These characteristics peaks of oxygen and nitrogen-containing biofunctional groups possibly confirm the tangible presence of polyphenol compounds39, alkaloids, chitosan40, polysaccharides41,42, protein, and other major water-soluble primary and secondary metabolites in a mixture of raw marine algae-chitosan extract43.
Figure 5.
FTIR spectra of (a) raw mixture of marine algae extract-chitosan and (b) green silver nanoparticles.
In context to the FTIR spectrum of AgNPs, the shift in position and reduction in the intensity of some bands such as is C=O, C‒N, O‒H, and even N‒H observed when compared to the marine algae-chitosan extract. These results indicate the effective electronic interaction between silver ions with nitrogen and oxygen-containing biomolecules in the algae-chitosan medium. It can be noted that biochemicals of the marine extract detected during FTIR analysis possibly act a dual function through bioreduction and long-term stabilization of freshly prepared AgNPs. They eventually handle the nucleation process and aggregation of metal nanoparticle during the synthesis process. Moreover, marine biochemicals involved in the synthesis of AgNPs are considered as key parameters in determining the size and distribution of nanoparticles.
EDX analysis
EDX spectroscopy was used in order to determine elemental composition which present in bioproduced AgNPs sample. Due to surface plasmon resonance, the EDX spectrum exhibits characteristic signals of silver element in the range of 2.6–3.4 keV which in turn confirms the formation of silver nanoparticles (Fig. 6)44. Moreover, the elemental analysis revealed metallic nature of silver which demonstrated the highest proportion of the metallic silver (88.15%) in the AgNPs. The presence of a weak O signal is perhaps due to the adsorbed oxygen species on the surface of fresh air-dried AgNPs. These results indicate that biofabricated AgNPs are highly pure, supporting XRD findings (Fig. 2).
Figure 6.

EDX spectrum of bioprepared silver nanoparticles using chitosan-algae extract.
Mechanism of AgNPs biosynthesis
The proposed mechanism for the biosynthesis of AgNPs using alga-chitosan extract mixture is illustrated in Fig. 7. The biofabrication of marine biomolecule-functionalized silver nanoparticles was accomplished using a spontaneous oxidation–reduction (donor–acceptor electron) reaction process38. Frequently, the O–H and N–H functional groups for upholding strong affinity towards metal ions consequently during oxidation, the enormous amount of electron donor amine and hydroxyl functional groups in chitosan and algae-derived polyphenolic compounds such as phlorotannins, dieckol, phloroglucinol, and eckol39,45 function as potential reducing and capping agents46 through transferring electrons to silver ions as an electron acceptor in the synthesis reaction. As the reaction progresses, electron-rich organic biomolecules increasingly lose their outer electrons while Ag+ cations gain the electrons and could be reduced to metallic atoms. In addition, surplus biomacromolecules could also serve as a surface protector27 of AgNPs via either electrostatic or steric repulsion, leading to aggregation prevention47 (Fig. 8). As a result, developing a combination of marine-based biopolymer chitosan and algae extract provides a simple and facile approach to establish an efficient and durable AgNPs that can enhance their antibacterial activity. These results are well consistent with the FTIR, TGA, TEM, zeta potential, and UV–vis findings.
Figure 7.
Proposed mechanism for synthesis of biogenic AgNPs from mixture algae extract and chitosan. Algae-derived polyphenolic biomolecules (Eckol as a model) and chitosan biopolymers play as a reductant.
Figure 8.
Simultaneous stabilization of AgNPs with marine-derived biomolecules.
Thermal analysis of functionalized AgNPs
Thermal stability and surface functionalization of biosynthesized AgNPs further investigated using a simultaneous thermogravimetric analysis analyzer (TGA). The samples of 7 mg were heated under a constant flow of nitrogen gas in the temperature range 25–800 °C at a heating rate of 10°/min. Figure 9 is illustrated comparatively the stages of mass loss in bioprepared AgNPs in TGA thermogram ranging from 50 to 430 °C. The results indicated mainly present two steps of thermal degradation. The primary degradation bioinspired AgNPs starting from 50 to 100 °C is anticipated to the evaporation of adsorbed water with a weight loss of about 10%. The initial degradation of bioconjugated organic species including carbohydrates, chitosan, polyols, peptides, and other various biochemical constitutes occurs at 250 °C and they were totally decomposed approximately around 430 °C with the highest weight loss of about 45% to corresponding original chitosan and algae. The TGA plot results eventually demonstrate that biological AgNPs surface was modified through covalent and non-covalent bioconjugation of umpteen marine biomolecules contained in the marine algae-chitosan extract, supporting FTIR results (Fig. 5)48. In an alike research, Selvaraj et al., have indicated that TGA analysis of green synthesized α-Fe2O3 nanoparticles using the leaf extract of Spondias dulcis revealed high thermal stability with only 28% weight loss, implying the reliability of biosynthetic routes49.
Figure 9.
TGA thermogram of marine-mediated silver nanoparticles using algae-chitosan extract showing weight loss (a) the evaporation of moistures and (b) the degradation of organic biomolecules.
Antibacterial activity of green functionalized AgNPs
The antibacterial efficiency of a variety of nanoparticles including combinatorial algae-chitosan extract-mediated AgNPs (hereafter, biological AgNPs), algae extract-assisted AgNPs, chemical AgNPs, chitosan-mediated AgNPs, and AgNO3 solution are depicted in Fig. 10. Disk diffusion results revealed that the algae-chitosan mixture extract-assisted AgNPs induce superior effectiveness for all selected gram-positive and gram-negative bacterial strains in comparison to the corresponding commercial silver nanoparticles (Figs. 4S–6S, see supplementary), initial algae-chitosan extract, chitosan, algae extract, and silver nitrate precursor, respectively (Fig. 10). The antimicrobial effects of biological AgNPs demonstrate that the largest zone of inhibition of bacterial growth and adhesion was observed on gram-negative E. coli bacteria with a mean diameter of 21 mm, followed by Proteus and Salmonella with a diameter of 20 and 18 mm whereas the minimum rate of bacterial mortality was related to gram-positive Bacillus cereus with a diameter of 17 mm. The results revealed that for all scrutinized pathogens the enhanced bactericidal activity of exploited nanoparticles tracks the same trend so that biological AgNPs > chitosan-mediate AgNPs > algae-mediate AgNPs > chemical AgNPs > algae-chitosan extract > AgNO3 as it is illustrated in Fig. 10. Yet, by measuring the zones of bacterial growth, the inhibition activity of biological AgNPs against gram-negative bacterial strains was fairly higher than Bacillus cereus as representative of pathogenic gram-positive bacteria50. These results present a different manner of bacteria toward applied nanoparticles, reflecting their specific adhesive interactions with bacteria-targeting nanoparticles51. In contrast to naked chemical AgNPs, the marine-derived biomolecules which encompass the surface of biological AgNPs would presumably enhance the biological applicability and biocompatibility of nanoparticles and hence increase the antibacterial properties of bioproduced nanoparticles. More interestingly, biogenic AgNPs could efficiently anchor to the microbial cell and infilter its membrane via sustainable releasing Ag+ in and out of bacteria which in turn leads to bacterial dysfunction and eventually destruction17. It is found that nanoparticles functionalized with biomolecule can significantly enhance antimicrobial activity52. Moreover, Stellacci and Ouay stated that surface properties of silver nanoparticles have a key effect on their potency since they influence chemical specificities such as passivation and dissolution as well as physical phenomena including aggregation and affinity for bacterial membrane53.
Figure 10.
Comparative inhibitory effect of various ecofriendly AgNPs, AgNO3, algae-chitosan extract, and commercial silver nanoparticles against the selected clinical pathogen, (A: biological AgNPs, B: chitosan-mediated AgNPs, C: algae-mediated AgNPs, D: chemical AgNPs, E: raw extract, F: AgNO3, and G: H2O).
Conclusion
Crystalline functionalized AgNPs were biosynthesized using marine-derived biomolecules in combinatorial extract of algae and chitosan. The designed biosynthetic method was succeeded in achieving the controlled size and shape of biogenic AgNPs. UV–Vis, XRD, EDX, DLS, and TEM techniques confirmed that FCC crystal structure of pure spherical Ag NP exhibits a prominent SPR band at 425 nm and having prolonged stability after 6 months of storage. FTIR and TGA revealed the involvement of electron-rich biomolecules in Ag+ cations bioreduction, surface modification, and thermal stability of final AgNPs products. In comparison to commercial naked AgNPs, raw algae-chitosan extract, and AgNO3 salt, biogenic AgNPs demonstrated synergistic antibacterial effects against five selected gram-negative as well as gram-positive bacterial strains owing to their enhanced bioavailability. Due to the efficiency, safety, cost-effectiveness, and readily available, this promising environmentally compatible synthetic method can be promoted as a reliable alternative to hazardous chemical procedures.
Materials and methods
Preparation of chitosan and silver nitrate solutions
Shrimp shell derived chitosan (M.W. 190,000–310,000 Da.) and silver nitrate compound provided by Sigma-Aldrich were used as the raw materials for the synthesis of silver nanoparticles. Distilled water was employed for making up all solutions. Chitosan solution (0.5%) was prepared by dissolving 0.5 g of chitosan powder in 100 ml of 2% acetic acid. Moreover, Silver nitrate 0.5% solution (0. 03 M) was produced by dissolving 0.5 g of silver nitrate in 100 ml of double-distilled water.
Algal biomass preparation
The biomass of marine brown algae (Sargassum angustifolium) was collected (250 g ± 2 g) in Spring from the depths of 1–2 m in the coasts of Bushehr province, Iran, and transferred to the laboratory in ice-containing plastic bags. The algae were washed three times with tap and distilled water to remove its mud and other impurities. Then, it was placed at room temperature for a week to be dried, then powdered with an agate mortar, and finally sieved by screen.
Preparation of aqueous extract of algae
1 g of algae powder was mixed with 100 ml of distilled water and placed on a magnetic stirrer at 100 °C for 20 min (cotton and foil were used to prevent vaporization). After cooling at the room temperature, it was centrifuged at 3500 rpm for 10 min and was passed through Whatman No 1 filter paper and stored in the refrigerator at 4 °C for more analyses.
Biosynthesis of AgNPs in algae extract and chitosan medium
30 ml of aqueous extract of algae, 2 ml of 0.5% chitosan, and 5 ml of silver nitrate 0.5% solutions (0.5 g) were mixed and placed in the autoclave at a pressure of 15 psi and temperature of 120 °C. Then, the effect of the concentration of each solution was examined by changing one parameter and keeping the other constant. To characterize the features of biosynthesized AgNPs, UV–Vis (Analytik-Jena AG, Germany), XRD (X'Pert PRO MPD, Panalytical Co., Netherlands), FTIR (BRUKER Alpha-Germany), TGA (PerkinElmer, Pyris 1, USA), DLS (Vasco/Cordouan Technologies, France), Zetasizer Nano ZS (ZEN3600, Malvern, UK), and TEM (BRUKER Alpha, Germany) techniques were utilized. The mean particle size of AuNPs was calculated by the Debye–Scherrer equation [Eq. (1)], where is the mean diameter of crystallite size, is the Scherrer constant with the value 0.9, is the wavelength of X-ray radiation (0.154 nm), is the full width at half the maximum intensity (FWHM), and is the Bragg angle.
| 1 |
Antibacterial activity
To investigate the antibacterial properties of the bioprepared AgNPs, a sterile disk diffusion method was used54. 2 g of nutrient agar culture medium was dissolved in 100 ml of distilled water and placed at the autoclave for sterilizing at 15 psi and 120 °C for 30 min. Then, the sterilized culture medium was transferred to the plates next to the flame. 100 µl of gram-negative bacteria including Escherichia coli (ATCC 11775), Salmonella enterica subsp. Enterica (ATCC 13076), Proteus sp. (ATCC 25933) and Gram-positive bacteria of Bacillus cereus (ATCC 14579) were cultured separately in a liquid medium. 50 µl of green AgNPs stock solution (400 μg/ml) was carefully transferred into the disks. Plates were placed in an incubator for 24 h at 37 °C. The mean diameter of inhibition zones was recorded by vernier caliper (mm) after three replications. In this experiments, distilled water utilized as negative control. The selected bacteria are relatively most widespread healthcare-associated infections which cause common illnesses in humans, including fever, abdominal pain, diarrhea, salmonellosis, sometimes nausea and vomiting55.
Stability test of nanoparticles
To investigate the stability of the synthesized AgNPs, they were maintained in a laboratory environment (25 °C) for 6 months. Foil and cotton were used to prevent solvent evaporation. The aged solution was tested by UV–vis technique.
Supplementary information
Acknowledgements
Authors would like to thank lab staff of Khorramshahr University of Marine Science and Technology for their technical support and assistance.
Author contributions
N.H.R. conducted experiments related to the AgNPs biosynthesis and antibacterial tests. F.B. supervised the study, designed the research framework, and carried out the data analysis. S.M. participated in setting up an experiment of antibacterial activity of AgNPs and analyzing results. The final manuscript has been written and edited by F.B. with contributions from all coauthors.
Competing interests
The authors declare no competing interests.
Footnotes
This article has been retracted. Please see the retraction notice for more detail: https://doi.org/10.1038/s41598-020-76726-7
Publisher's note
Springer Nature remains neutral with regard to jurisdictional claims in published maps and institutional affiliations.
Change history
10/21/2024
Editor’s Note: Readers are alerted that concerns have been raised regarding the reliability of data presented in this article. Further editorial action will be taken if appropriate once the investigation into the concerns is complete and all parties have been given an opportunity to respond in full.
Change history
2/23/2021
A Correction to this paper has been published: 10.1038/s41598-021-84489-y
Change history
12/16/2025
This article has been retracted. Please see the Retraction Notice for more detail: 10.1038/s41598-025-30800-0
Supplementary information
is available for this paper at 10.1038/s41598-020-76726-7.
References
- 1.Karn, B. & Wong, S. S. Sustainable Nanotechnology and the Environment: Advances and Achievements 1–10 (ACS Publications, Washington, DC, 2013). [Google Scholar]
- 2.Buazar, F., Sweidi, S., Badri, M. & Kroushawi, F. Biofabrication of highly pure copper oxide nanoparticles using wheat seed extract and their catalytic activity: a mechanistic approach. Green Process. Synth.8, 691–702 (2019). [Google Scholar]
- 3.Akhtar, M. S., Panwar, J. & Yun, Y.-S. Biogenic synthesis of metallic nanoparticles by plant extracts. ACS Sustain. Chem. Eng.1, 591–602 (2013). [Google Scholar]
- 4.Shah, M., Fawcett, D., Sharma, S., Tripathy, S. K. & Poinern, G. E. J. Green synthesis of metallic nanoparticles via biological entities. Materials8, 7278–7308 (2015). [DOI] [PMC free article] [PubMed] [Google Scholar]
- 5.Manikandan, R., Kavitha, R., Pan, W., Elanchezhian, M. & Selvakumar, S. Biogenic synthesis of nanoparticles and their environmental applications. Biol. Synth. Nanoparticles Appl.2, 121 (2020). [Google Scholar]
- 6.Vinayagam, R., Selvaraj, R., Arivalagan, P. & Varadavenkatesan, T. Synthesis, characterization and photocatalytic dye degradation capability of Calliandra haematocephala-mediated zinc oxide nanoflowers. J. Photochem. Photobiol. B Biol.203, 111760 (2020). [DOI] [PubMed] [Google Scholar]
- 7.Varadavenkatesan, T. et al. Photocatalytic degradation of Rhodamine B by zinc oxide nanoparticles synthesized using the leaf extract of Cyanometra ramiflora. J. Photochem. Photobiol. B Biol.199, 111621 (2019). [DOI] [PubMed] [Google Scholar]
- 8.Anchan, S. et al. Biogenic synthesis of ferric oxide nanoparticles using the leaf extract of Peltophorum pterocarpum and their catalytic dye degradation potential. Biocatal. Agric. Biotechnol.20, 101251 (2019). [Google Scholar]
- 9.Pai, S., Sridevi, H., Varadavenkatesan, T., Vinayagam, R. & Selvaraj, R. Photocatalytic zinc oxide nanoparticles synthesis using Peltophorum pterocarpum leaf extract and their characterization. Optik185, 248–255 (2019). [Google Scholar]
- 10.LewisOscar, F. et al. Algal nanoparticles: synthesis and biotechnological potentials. Algae Organ. Imminent Biotechnol.7, 157–182 (2016). [Google Scholar]
- 11.Fawcett, D., Verduin, J. J., Shah, M., Sharma, S. B. & Poinern, G. E. J. A review of current research into the biogenic synthesis of metal and metal oxide nanoparticles via marine algae and seagrasses. J. Nanosci. 2017, 1–15 (2017). [Google Scholar]
- 12.Wang, W. et al. Chitosan derivatives and their application in biomedicine. Int. J. Mol. Sci.21, 487 (2020). [DOI] [PMC free article] [PubMed] [Google Scholar]
- 13.Wei, S., Ching, Y. C. & Chuah, C. H. Synthesis of chitosan aerogels as promising carriers for drug delivery: a review. Carbohyd. Polym.231, 115744 (2020). [DOI] [PubMed] [Google Scholar]
- 14.Almalik, A. et al. Hyaluronic acid coated chitosan nanoparticles reduced the immunogenicity of the formed protein corona. Sci. Rep.7, 1–9 (2017). [DOI] [PMC free article] [PubMed] [Google Scholar]
- 15.Mirzazadeh, T. F. S. et al. Controlling evolution of protein corona: a prosperous approach to improve chitosan-based nanoparticle biodistribution and half-life. Sci. Rep. (Nature Publisher Group)10, 1–4 (2020). [DOI] [PMC free article] [PubMed] [Google Scholar]
- 16.Walsh, C. & Wencewicz, T. Antibiotics: Challenges, Mechanisms, Opportunities (Wiley, New York, 2020). [Google Scholar]
- 17.Sánchez-López, E. et al. Metal-based nanoparticles as antimicrobial agents: an overview. Nanomaterials10, 292 (2020). [DOI] [PMC free article] [PubMed] [Google Scholar]
- 18.Alarcon, E. I., Griffith, M. & Udekwu, K. I. Silver Nanoparticle Applications (Springer, Berlin, 2015). [Google Scholar]
- 19.Tarannum, N. & Gautam, Y. K. Facile green synthesis and applications of silver nanoparticles: a state-of-the-art review. RSC Adv.9, 34926–34948 (2019). [DOI] [PMC free article] [PubMed] [Google Scholar]
- 20.Ramalingam, B., Parandhaman, T. & Das, S. K. Antibacterial effects of biosynthesized silver nanoparticles on surface ultrastructure and nanomechanical properties of gram-negative bacteria viz. Escherichia coli and Pseudomonas aeruginosa. ACS Appl. Mater. Interfaces8, 4963–4976 (2016). [DOI] [PubMed] [Google Scholar]
- 21.Karthik, L., Kirthi, A. V., Ranjan, S. & Srinivasan, V. M. Biological Synthesis of Nanoparticles and Their Applications (CRC Press, Boca Raton, 2020). [Google Scholar]
- 22.Srikar, S. K., Giri, D. D., Pal, D. B., Mishra, P. K. & Upadhyay, S. N. Green synthesis of silver nanoparticles: a review. Green Sustain. Chem.6, 34–56 (2016). [Google Scholar]
- 23.Sahariah, P. & Masson, M. Antimicrobial chitosan and chitosan derivatives: a review of the structure–activity relationship. Biomacromol18, 3846–3868 (2017). [DOI] [PubMed] [Google Scholar]
- 24.Kumar, M. R., Muzzarelli, R., Muzzarelli, C., Sashiwa, H. & Domb, A. Chitosan chemistry and pharmaceutical perspectives. Chem. Rev.104, 6017–6084 (2004). [DOI] [PubMed] [Google Scholar]
- 25.Koopi, H. & Buazar, F. A novel one-pot biosynthesis of pure alpha aluminum oxide nanoparticles using the macroalgae Sargassum ilicifolium: a green marine approach. Ceram. Int.44, 8940–8945 (2018). [Google Scholar]
- 26.Shukla, A. K. & Iravani, S. Green Synthesis, Characterization and Applications of Nanoparticles (Elsevier, Amsterdam, 2018). [Google Scholar]
- 27.Kahrilas, G. A. et al. Microwave-assisted green synthesis of silver nanoparticles using orange peel extract. ACS Sustain. Chem. Eng.2, 367–376 (2014). [Google Scholar]
- 28.Gahlawat, G. & Choudhury, A. R. A review on the biosynthesis of metal and metal salt nanoparticles by microbes. RSC Adv.9, 12944–12967 (2019). [DOI] [PMC free article] [PubMed] [Google Scholar]
- 29.Varadavenkatesan, T., Selvaraj, R. & Vinayagam, R. Green synthesis of silver nanoparticles using Thunbergia grandiflora flower extract and its catalytic action in reduction of Congo red dye. Mater. Today Proc.23, 39–42 (2020). [Google Scholar]
- 30.Helmlinger, J. et al. On the crystallography of silver nanoparticles with different shapes. Cryst. Growth Des.16, 3677–3687 (2016). [Google Scholar]
- 31.Vanaja, M. & Annadurai, G. Coleus aromaticus leaf extract mediated synthesis of silver nanoparticles and its bactericidal activity. Appl. Nanosci.3, 217–223 (2013). [Google Scholar]
- 32.Vinayagam, R., Varadavenkatesan, T. & Selvaraj, R. Green synthesis, structural characterization, and catalytic activity of silver nanoparticles stabilized with Bridelia retusa leaf extract. Green Process. Synth.7, 30–37 (2018). [Google Scholar]
- 33.Yadav, P., Manjunath, H. & Selvaraj, R. Antibacterial and dye degradation potential of zero-valent silver nanoparticles synthesised using the leaf extract of Spondias dulcis. IET Nanobiotechnol.13, 84–89 (2018). [DOI] [PMC free article] [PubMed] [Google Scholar]
- 34.Sapsford, K. E., Tyner, K. M., Dair, B. J., Deschamps, J. R. & Medintz, I. L. Analyzing nanomaterial bioconjugates: a review of current and emerging purification and characterization techniques. Anal. Chem.83, 4453–4488 (2011). [DOI] [PubMed] [Google Scholar]
- 35.Tomaszewska, E. et al. Detection limits of DLS and UV-Vis spectroscopy in characterization of polydisperse nanoparticles colloids. J. Nanomater.2013, 1–10 (2013). [Google Scholar]
- 36.Varadavenkatesan, T., Vinayagam, R. & Selvaraj, R. Green synthesis and structural characterization of silver nanoparticles synthesized using the pod extract of Clitoria ternatea and its application towards dye degradation. Mater. Today Proc.23, 27–29 (2020). [Google Scholar]
- 37.Anandalakshmi, K., Venugobal, J. & Ramasamy, V. Characterization of silver nanoparticles by green synthesis method using Pedalium murex leaf extract and their antibacterial activity. Appl. Nanosci.6, 399–408 (2016). [Google Scholar]
- 38.Khalafi, T., Buazar, F. & Ghanemi, K. Phycosynthesis and enhanced photocatalytic activity of zinc oxide nanoparticles toward organosulfur pollutants. Sci. Rep.9, 1–10 (2019). [DOI] [PMC free article] [PubMed] [Google Scholar]
- 39.Freile-Pelegrín, Y. & Robledo, D. Bioactive phenolic compounds from algae. In Bioactive Compounds from Marine Foods: Plant and Animal Sources (eds Hernández-Ledesma, B. & Herrero, M.) 113–129 (Wiley, New York, 2013). [Google Scholar]
- 40.Biao, L. et al. Synthesis, characterization and antibacterial study on the chitosan-functionalized Ag nanoparticles. Mater. Sci. Eng. C76, 73–80 (2017). [DOI] [PubMed] [Google Scholar]
- 41.Khanna, P., Kaur, A. & Goyal, D. Algae-based metallic nanoparticles: synthesis, characterization and applications. J. Microbiol. Methods163, 105656 (2019). [DOI] [PubMed] [Google Scholar]
- 42.Usman, A., Khalid, S., Usman, A., Hussain, Z. & Wang, Y. Algae Based Polymers, Blends, and Composites 115–153 (Elsevier, Amsterdam, 2017). [Google Scholar]
- 43.Fernandes Queiroz, M., Melo, K. R. T., Sabry, D. A., Sassaki, G. L. & Rocha, H. A. O. Does the use of chitosan contribute to oxalate kidney stone formation?. Mar. Drugs13, 141–158 (2015). [DOI] [PMC free article] [PubMed] [Google Scholar]
- 44.Vanaja, M. et al. Degradation of methylene blue using biologically synthesized silver nanoparticles. Bioinorg. Chem. Appl.2014, 1–8 (2014). [DOI] [PMC free article] [PubMed] [Google Scholar]
- 45.Zhang, D. et al. Comparative analysis of oxidative mechanisms of phloroglucinol and dieckol by electrochemical, spectroscopic, cellular and computational methods. RSC Adv.8, 1963–1972 (2018). [DOI] [PMC free article] [PubMed] [Google Scholar]
- 46.Matussin, S., Harunsani, M. H., Tan, A. L. & Khan, M. M. Plant-extract-mediated SnO2 nanoparticles: synthesis and applications. ACS Sustain. Chem. Eng.8, 3040–3054 (2020). [Google Scholar]
- 47.Roy, B., Mukherjee, S., Mukherjee, N., Chowdhury, P. & Babu, S. P. S. Design and green synthesis of polymer inspired nanoparticles for the evaluation of their antimicrobial and antifilarial efficiency. RSC Adv.4, 34487–34499 (2014). [Google Scholar]
- 48.Sapsford, K. E. et al. Functionalizing nanoparticles with biological molecules: developing chemistries that facilitate nanotechnology. Chem. Rev.113, 1904–2074 (2013). [DOI] [PubMed] [Google Scholar]
- 49.Vinayagam, R. et al. Structural characterization of green synthesized α-Fe2O3 nanoparticles using the leaf extract of Spondias dulcis. Surf. Interfaces20, 100618 (2020). [Google Scholar]
- 50.Mohanbaba, S. & Gurunathan, S. Nanobiomaterials in Antimicrobial Therapy 193–227 (Elsevier, Amsterdam, 2016). [Google Scholar]
- 51.Spengler, C. et al. Strength of bacterial adhesion on nanostructured surfaces quantified by substrate morphometry. Nanoscale11, 19713–19722 (2019). [DOI] [PubMed] [Google Scholar]
- 52.Veerapandian, M. & Yun, K. Functionalization of biomolecules on nanoparticles: specialized for antibacterial applications. Appl. Microbiol. Biotechnol.90, 1655–1667 (2011). [DOI] [PubMed] [Google Scholar]
- 53.Le Ouay, B. & Stellacci, F. Antibacterial activity of silver nanoparticles: a surface science insight. Nano Today10, 339–354 (2015). [Google Scholar]
- 54.Ruparelia, J. P., Chatterjee, A. K., Duttagupta, S. P. & Mukherji, S. Strain specificity in antimicrobial activity of silver and copper nanoparticles. Acta Biomater.4, 707–716 (2008). [DOI] [PubMed] [Google Scholar]
- 55.Achtman, M. Multiple Time Scales for Dispersals of Bacterial Disease Over Human History. Nicole Boivin/Rémy Crassard/Michael Petraglia (Hg.), Human Dispersal and Species Movement. From Prehistory to the Present, Cambridge 454–476 (2017).
Associated Data
This section collects any data citations, data availability statements, or supplementary materials included in this article.